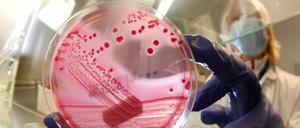

Eine Lücke ist geschlossen: Nun gehört das gesamte deutsche Wattenmeer zum Welterbe. Wie auch prähistorische Pfahlbauten in Baden-Württemberg und Bayern erhielt der Nationalpark Hamburgisches Wattenmeer den prestigeträchtigen Titel.

Eine Lücke ist geschlossen: Nun gehört das gesamte deutsche Wattenmeer zum Welterbe. Wie auch prähistorische Pfahlbauten in Baden-Württemberg und Bayern erhielt der Nationalpark Hamburgisches Wattenmeer den prestigeträchtigen Titel.
Wie ein Abgeordneter das Atomdilemma erlebt
Mit zwei Turnieren um den Beelitzer Spargelcup bietet die SG Blau-Weiß Beelitz an diesem Wochenende einen attraktiven Höhepunkt zum Saisonausklang. Zur vierten Auflage dieses Events werden Juniorenteams aus Berlin, Sachsen-Anhalt, Sachsen, Mecklenburg-Vorpommern, Thüringen, Niedersachsen und Brandenburg erwartet.
Babelsbergs Motor-Judoka wollen in Holle punkten

Jetzt werden betroffene Sprossenarten eingekreist. Eventuell sind auch Samen und dadurch selbst gezogenes Gemüse mit dem Ehec-Erreger belastet.

In der Mülltonne einer durch Ehec-Bakterien erkrankten Familie in Nordrhein-Westfalen haben die Behörden Sprossen mit dem aggressiven Erreger gefunden. Sie stammen vom Biohof in Bienenbüttel.

In Magdeburg wird eine infizierte Gurke gefunden, der Krisengipfel in Berlin macht auf Harmonie. Wo stehen wir bei der Ehec-Epidemie?

Auf einem Gurkenrest in einer Mülltonne in Magdeburg haben Experten eine mutierte Form des Ehec-Keims nachgewiesen. Die Tonne gehört einer Familie, die an Ehec erkrankt ist. Die Spur kann aber offenbar nicht weiter verfolgt werden.
Die Gesundheitsministerien der Länder äußern sich bisher nicht: Verspeisten die 2325 registrierten Ehec-Patienten nun großenteils Sprossen, ja oder nein? In dem Tohuwabohu der Behörden ist eine andere Warnung vollkommen untergegangen.
Nach Sprossen hat möglicherweise einfach niemand gefragt

UPDATE. Gesundheitsministerium: Zahl der Infektionen wieder leicht gestiegen. EU will Bauern entschädigen und der Bundestag wird sich am Freitag mit dem Ehec-Krisenmanagement befassen.
Der Auslöser der Infektion ist noch nicht gefunden. Auch die von einem Hamburger Patienten bei den Behörden abgegebene Sprossen-Probe weist keine Ehec-Keime auf. Die Kritik am Krisenmanagement wird derweil lauter - auch aus der EU. Was läuft falsch?

Die "german angst" diktiert die Gesetze und verschließt vor realen Risiken die Augen. Die Ehec-Epidemie zeigt, dass es die Natur ist, von der die eigentliche Gefahr in der Nahrung ausgeht - allem Öko-Kitsch zum Trotz.
ie "german angst" diktiert die Gesetze und verschließt vor realen Risiken die Augen. Die Ehec-Epidemie zeigt, dass es die Natur ist, von der die eigentliche Gefahr in der Nahrung ausgeht - allem Öko-Kitsch zum Trotz.
Nach Tagesspiegel-Informationen haben Forscher einen Durchbruch bei der Charakterisierung des Ehec-Erregers erzielt. Untersuchungen zeigen: Wiederkäuer sind wohl nicht die Quelle.
Der amtierende Umweltminister, Norbert Röttgen (CDU), hat am Montag auf das Offensichtliche hingewiesen. Beim Festakt zum 25.

Walter Wallmann war der erste Chef: Seit 25 Jahren gibt es das Bundesumweltministerium. Eine Krise stand schon damals Pate

Sprossen galten zuletzt als Quelle des Darmkeims Ehec, doch erste Proben weisen nun keine Spuren auf. Bundesverbraucherschutzministerin Aigner rät trotzdem zunächst weiter von dem Verzehr von Sprossen ab.

Bei der Suche nach der Quelle für die lebensgefährliche Ehec-Epidemie führt eine erste konkrete Spur zu einem Gartenbaubetrieb in Niedersachsen. Sprossen könnten die Ursache der schweren Erkrankungen sein.
Die Experten sind sich ziemlich sicher. Auch wenn der letzte Beweis fehlt: Sprossengemüse aus Niedersachsen ist wohl dafür verantwortlich, dass Ehec grassiert. Ob alle gefährlichen Sprossen bereits verzehrt sind, ist unbekannt.

Fieberhaft fahnden Ärzte, Forscher und Gesundheitsexperten nach den Ursachen der Ehec-Seuche – die immer stärker zunimmt. Der Ausbruch wirft zahlreiche Fragen auf.
Bundesamt genehmigt letzten Transport – weitere Castoren aus Frankreich nicht zu erwarten

Ärzte haben das Erbgut des Ehec-Bakteriums sequenziert. Die Zahl der am Erreger gestorbenen Menschen in Deutschland ist auf 17 gestiegen. Russland hat ein Importstopp für Gemüse aus EU-Ländern verhängt.

Die Zahl der Erkrankungen am Darmerreger EHEC hat vor allem in Norddeutschland rasant zugenommen. Aber auch in Berlin steigt die Zahl. Und noch immer herrscht Unklarheit über die Ursache.

Die Bundesregierung muss sich bei ihrem Versuch, die Bundesländer für ihr Konzept zum Atomausstieg zu gewinnen, auf Widerstand auch aus den eigenen Reihen einstellen.

Das deutsche Forschungsschiff "Sonne" bekommt eine Nachfolgerin. Unter gleichem Namen soll sie 2015 erstmals zu einer Expedition aufbrechen.
Überraschende Wende bei den Ermittlungen zum Anschlag von Talokan: Die sieben deutschen und afghanischen Opfer wurden offenbar nicht von einem uniformierten Selbstmordattentäter, sondern von einer ferngezündeten Bombe in den Tod gerissen.
In Nordrhein-Westfalen ist eine 91-jährige Frau an den Folgen einer EHEC-Infektion gestorben. Die Zahl der Neuerkrankungen sei indessen rückläufig, heißt es aus Hamburg.
Nachts haben Union und FDP ihren Fahrplan für den Atomausstieg festgelegt, am Morgen gibt es die nächste Wende. CSU-Chef Seehofer will deutschlandweit ein Atommüll-Endlager suchen. Bisher galt Gorleben als schwarz-gelber Favorit.

Mehr Tote, weitere Kranke: In Lübeck stirbt eine ältere Frau. Ihr Ehemann liegt mit der gefährlichen Darminfektion im selben Krankenhaus. Die Deutschen verzichten derzeit mehrheitlich auf rohe Tomaten, Gurken und Salat.

Die Bauern im Norden Deutschlands werfen wegen des EHEC-Erregers tonnenweise Salatköpfe, Tomaten und Gurken auf den Müll. Obwohl spanische Importgurken als ein Träger des Darmkeims identifiziert worden sind, seien die Verbraucher bei deutschem Gemüse weiter skeptisch.
Die CDU soll sich auf ihrem Bundesparteitag im November offiziell von der Hauptschule verabschieden. Diesen Vorschlag will Sachsens Kultusminister Roland Wöller dem Parteivorstand machen, wie er der „Welt“ sagte.

Immer mehr Menschen erkranken am EHEC-Erreger, einer schweren Durchfallerkrankung. Nach wie vor suchen die Behörden nach dem Auslöser für die Infektionen.

stellt Musterhaus vor
Innenminister Friedrich stellt die Kriminalstatistik 2010 vor: Die Gesamtzahl der registrierten Straftaten in Deutschland ist auf den tiefsten Stand seit der Wiedervereinigung gefallen. Aber im Detail bleibt vieles besorgniserregend.
Spitzenplatz im Qualitätspakt für Lehre
Hannover 96 – 1. FC Nürnberg 3:1

Plötzlich ein neuer Ton. Keine Kampfansage, keine Hybris. Philipp Rösler setzt auf den geräuscharmen Liberalismus. Die FDP dankt es ihm mit Ovationen und Freudentränen. Fragt sich nur: Kann sich so viel Nettigkeit auch durchsetzen?

Daniel Libeskind hat für sein Osnabrücker Felix-Nussbaum-Museum einen Anbau geschaffen

VfL-Handballer beim 37:30 über Hildesheim mit Glanzleistung / Drechsler vor Wechsel nach Potsdam
öffnet in neuem Tab oder Fenster